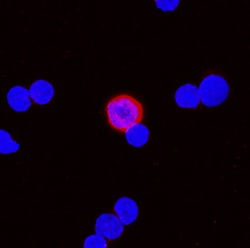
BST-2/Tetherin Rat anti-Mouse, Clone: 44E9R, R D Systems 25&mu;g; Unlabeled,

missing translation for 'onlineSavingsMsg'
Learn More
Learn More
BST-2/Tetherin Rat anti-Mouse, Clone: 44E9R, R&D Systems™


Rat Monoclonal Antibody
Brand: R&D Systems MAB8660-SP

This item is not returnable.
View return policy
Description
BST2 Monoclonal specifically detects BST2 in Mouse samples. It is validated for Flow Cytometry, Immunocytochemistry, CyTOF-ready.Specifications
| BST2 | |
| Monoclonal | |
| Unconjugated | |
| Lyophilized from a 0.2 μm filtered solution in PBS with Trehalose. *Small pack size (SP) is supplied as a 0.2 μm filtered solution in PBS. with No Preservative | |
| Bst2 | |
| Recombinant extracellular domain of CD317 | |
| 25 μg | |
| Primary | |
| Detects mouse BST-2/Tetherin in flow cytometry. | |
| Mouse | |
| Purified |
| Flow Cytometry, Immunocytochemistry, CyTOF | |
| 44E9R | |
| Flow Cytometry 0.25 ug/10^6 cells, Immunocytochemistry 8-25 ug/mL, CyTOF-ready | |
| bone marrow stromal antigen 2, bone marrow stromal cell antigen 2, BST2, BST-2, CD317, CD317 antigen, HM1.24 Antigen, NPC-A-7, PDCA-1, Tetherin | |
| Rat | |
| Protein A or G purified from cell culture supernatant | |
| RUO | |
| 684 | |
| Reconstitute at 0.5 mg/mL in sterile PBS. | |
| Use a manual defrost freezer and avoid repeated freeze-thaw cycles. 12 months from date of receipt, -20 to -70 degreesC as supplied. 1 month, 2 to 8 degreesC under sterile conditions after reconstitution. 6 months, -20 to -70 degreesC under sterile conditions after reconstitution. | |
| IgG2a |
Product Title
By clicking Submit, you acknowledge that you may be contacted by Fisher Scientific in regards to the feedback you have provided in this form. We will not share your information for any other purposes. All contact information provided shall also be maintained in accordance with our Privacy Policy.
Spot an opportunity for improvement?